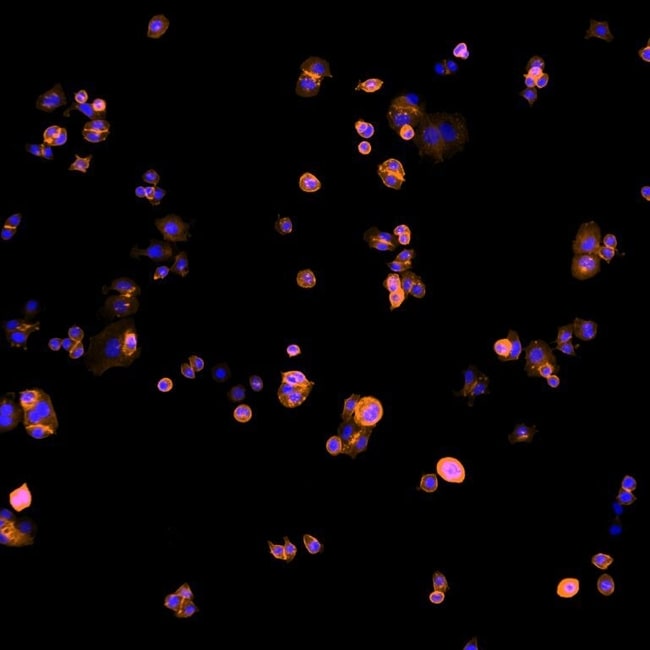
Thermo Fisher Scientific Goat anti-Human IgG (H+L) Cross-Adsorbed Secondary Antibody, Alexa Fluor Plus 594

Thermo Fisher Scientific Goat anti-Human IgG (H+L) Cross-Adsorbed Secondary Antibody, Alexa Fluor Plus 594
Alexa Fluor Plus 594로 결합된 염소 유래 항-인간 IgG(H+L) 2차 항체로, 높은 특이성과 낮은 배경 신호를 제공합니다. 인간 IgG 및 모든 면역글로불린의 중쇄·경쇄에 결합하며, ICC/IF 실험에 최적화되어 있습니다. 교차흡착 처리로 비특이적 반응 최소화.
✨AI 추천 연관 상품
AI가 분석한 이 상품과 연관된 추천 상품들을 확인해보세요
연관 상품을 찾고 있습니다...
Thermo Fisher Scientific Goat anti-Human IgG (H+L) Cross-Adsorbed Secondary Antibody, Alexa Fluor Plus 594
Applications
- Immunocytochemistry (ICC/IF): 1–10 µg/mL
Product Specifications
| 항목 | 내용 |
|---|---|
| Species Reactivity | Human |
| Host / Isotype | Goat / IgG |
| Class | Polyclonal |
| Type | Secondary Antibody |
| Immunogen | Gamma Immunoglobins Heavy and Light chains |
| Conjugate | Alexa Fluor™ Plus 594 |
| Excitation / Emission Max | 590 / 618 nm |
| Form | Liquid |
| Concentration | 2 mg/mL |
| Purification | Affinity chromatography |
| Storage Buffer | Proprietary buffer, pH 6.5 |
| Contains | 0.016% Methylisothiazolone, 0.016% Bromonitrodioxane |
| Storage Conditions | 4°C, store in dark |
| Shipping Conditions | Ambient (domestic); Wet ice (international) |
| RRID | AB_2896342 |
| Target | IgG |
| Cross Adsorption | Against serum proteins from bovine, mouse, and rabbit |
| Antibody Form | Whole Antibody |
Product Specific Information
본 항체는 비특이적 반응을 최소화하기 위해 소, 마우스, 토끼 혈청 단백질에 대해 교차흡착 처리되었습니다. 교차흡착은 항체 특이성을 높이는 정제 단계로, 배경 염색과 교차 반응을 줄여줍니다.
교차흡착 과정은 비특이적 결합 항체를 제거하고 고특이적 항체만 통과시키는 방식으로 수행됩니다. 이러한 추가 정제 단계는 다중 염색 및 형광 실험에서 다른 항체와의 교차반응을 줄이는 데 유용합니다.
사용 방법:
- 사용 전 단백질 결합 용액을 마이크로원심분리기로 짧게 원심분리 후 상등액만 사용하십시오.
- 적절한 항체 희석 배율은 실험 조건에 따라 경험적으로 결정해야 합니다.
특이성:
이 항체는 인간 IgG의 중쇄 및 모든 면역글로불린의 경쇄에 결합하며, 비면역글로불린 혈청 단백질이나 소·마우스·토끼의 혈청 단백질/IgG에는 결합하지 않습니다.
Target Information
Anti-Human secondary antibody는 인간 면역글로불린에 대한 특이성을 가진 친화정제 항체로, 검출·분류·정제에 활용됩니다.
2차 항체는 다양한 검출 시스템(HRP, AP, 형광 등)에 적용 가능하며, 신호 증폭을 통해 높은 민감도를 제공합니다.
일반적으로 숙주 동물에 표적 종의 면역글로불린을 면역하여 생성하며, 친화 크로마토그래피, 항체 절편화, 라벨 결합 등을 통해 높은 특이성의 시약으로 정제됩니다.
주의:
For Research Use Only. Not for use in diagnostic procedures. Not for resale without express authorization.
Additional Formats
- Alexa Fluor 488
- Alexa Fluor 546
- Alexa Fluor 555
- Alexa Fluor 568
- Alexa Fluor 594
- Alexa Fluor 633
- Alexa Fluor 647
- Alexa Fluor Plus 405
- Alexa Fluor Plus 488
- Alexa Fluor Plus 555
- Alexa Fluor Plus 647
- AP
- Biotin
- FITC
- HRP
- Rhodamine
- TRITC
- Request custom conjugation
제품 이미지

🏷️Thermo Fisher Scientific 상품 둘러보기
동일 브랜드의 다른 상품들을 확인해보세요

Thermo Fisher Scientific
Thermo Fisher Scientific F(ab`)2-Goat anti-Rabbit IgG (H+L) Cross-Adsorbed Secondary Antibody, Alexa Fluor Plus 488
298,200원

Thermo Fisher Scientific
Thermo Fisher Scientific Goat anti-Human IgG (H+L) Cross-Adsorbed Secondary Antibody, Alexa Fluor Plus 555
557,200원

Thermo Fisher Scientific
Thermo Fisher Scientific Goat anti-Human IgG (H+L) Cross-Adsorbed Secondary Antibody, Alexa Fluor Plus 594
525,000원

Thermo Fisher Scientific
Thermo Fisher Scientific Donkey anti-Rat IgG (H+L) Highly Cross-Adsorbed Secondary Antibody, Alexa Fluor Plus 647
258,100원

Thermo Fisher Scientific
Thermo Fisher Scientific Donkey anti-Rat IgG (H+L) Highly Cross-Adsorbed Secondary Antibody, Alexa Fluor Plus 594
525,000원
배송/결제/교환/반품 안내
배송 정보
| 기본 배송비 |
| 교환/반품 배송비 |
|
|---|---|---|---|
| 착불 배송비 |
| ||
| 교환/반품 배송비 |
| ||
결제 및 환불 안내
| 결제수단 |
|
|---|---|
| 취소 |
|
| 반품 |
|
| 환급 |
|
교환 및 반품 접수
| 교환 및 반품 접수 기한 |
|
|---|---|
| 교환 및 반품 접수가 가능한 경우 |
|
| 교환 및 반품 접수가 불가능한 경우 |
|
교환 및 반품 신청
| 교환 절차 |
|
|---|---|
| 반품 절차 |
|